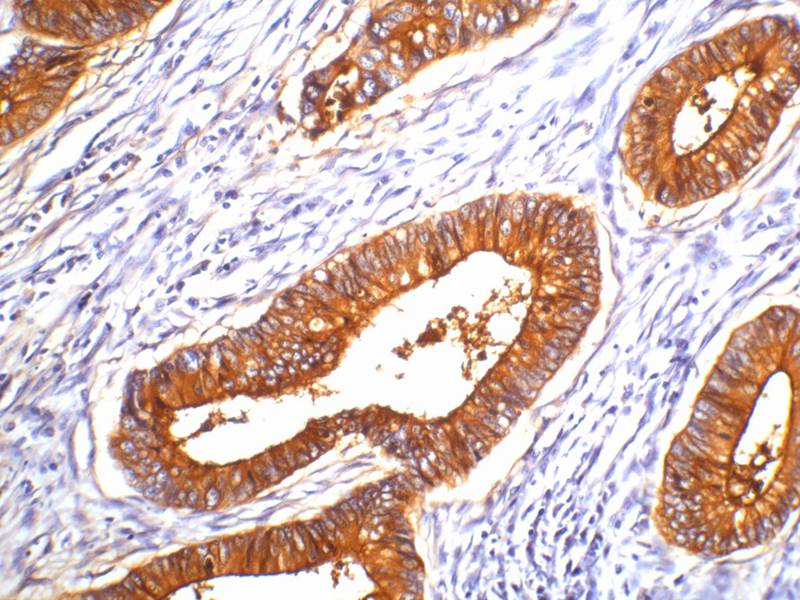
产品细节图片1

相关产品推荐更多 >
万千商家帮你免费找货
0 人在求购买到急需产品
- 详细信息
- 文献和实验
- 技术资料
- 形态:
liquid
- 保存条件:
Store at -20˚C
- 克隆性:
Monoclonal
- 适应物种:
Human
- 保质期:
12 months
- 抗原来源:
Mouse
- 供应商:
南京赛戈巍生物科技有限公司
- 宿主:
Mouse
- 应用范围:
IHC
- 靶点:
Uniprot:P11465
- 抗体英文名:
Carcinoembryonic Antigen(CEA) Mouse Monoclonal Antibody
- 规格:
50ul/100ul
配方:Mouse IgG1 in phosphate buffered saline (without Mg2+ and Ca2+), pH 7.4, 150mM NaCl, 0.02% sodium azide and 50% glycerol.
应用详情:Immunohistochemistry: 1:200
图片:
IHC staining of human colon cancer tissue with CEA mouse mAb(10E1) diluted at 1:200.
风险提示:丁香通仅作为第三方平台,为商家信息发布提供平台空间。用户咨询产品时请注意保护个人信息及财产安全,合理判断,谨慎选购商品,商家和用户对交易行为负责。对于医疗器械类产品,请先查证核实企业经营资质和医疗器械产品注册证情况。
文献和实验Antigen Purification by Monoclonal Antibody Immunoaffinity Chromatography
proteins. Taking advantage of the exquisite specificity afforded by each antibody results in a final purified product that binds specifically to that MAb. Using immunoaffinity chromatography, a single antigen can be separated from very complex mixtures (e.g
Monoclonal Antibody Production
Order 6 six week old Balb/C mice and let the ARC know they are coming.Have your antigen ready for when they arrive.Once they get there earmark the mice and perform a pre-bleed on them to be used as an ELISA control for monitoring the titer
Monoclonal Antibody Production Protocol
complete with MCM instead of PCM (= IMDM - m ), and keep it in the incubator for fused cells. Isolation of spleen cells Sacrifice mouse by cervical dislocation. Immerse mouse in 70% Ethanol. Remove spleen ( on the left side ) and transfer into a small
技术资料暂无技术资料 索取技术资料






![SMC4 Antibody[37957]](https://img1.dxycdn.com/p/s14/2025/0922/359/6146153295428599691.jpg!wh200)
![GLMN Conjugated Antibody[C37595]](https://img1.dxycdn.com/p/s14/2025/0923/278/4431488150116040791.jpg!wh200)
![Dynamin 2 Conjugated Antibody[C49613]](https://img1.dxycdn.com/p/s14/2025/0923/305/2150219664296040791.jpg!wh200)

